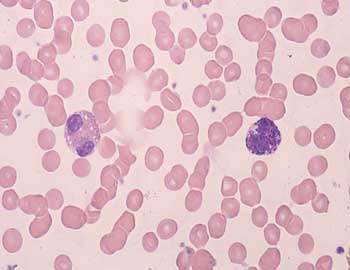

Microscopía de las células del sistema inmunitario
INM-0
Extensión sanguínea (Giemsa) |
Visión general: hemos seleccionado una extensión de sangre periférica para analizar los diferentes elementos formes de la sangre.
Visión específica: el análisis citológico muestra la existencia de distintos elementos formes: eritrocitos o partículas anucleadas eosinófilas, como componente mayoritario; leucocitos polimorfonucleares con gránulos neutrófilos, eosinófilos y basófilos así como pequeños agregados de corpúsculos plaquetarios. Los núcleos de los granulocitos, de cromatina densa, presentan lobulaciones. Generalmente se pueden observar de 3 a 5 en los granulocitos neutrófilos, y en menor número y en ocasiones parcialmente ocultas en los granulocitos eosinófilos y basófilos. Asimismo y en menor proporción que los leucocitos, se aprecian linfocitos maduros de pequeño tamaño con núcleo redondeado y cuyo citoplasma quedan limitado a un fino ribete, así como monocitos de mayor tamaño y citoplasma más amplio con núcleo hendido.
 |
 |
INM-0 Neutrófilos (Giemsa) 100x |
 |
INM-0 Eosinófilo (Giemsa) 100x |
 |
|
|
INM-0 Eosinófilo y basófilo (Giemsa) 100x |
 |
|
Vídeo
INM-1
Piel gruesa (Hematoxilina-eosina) |
Visión general: fragmento de epidermis y dermis. Se observa tanto el tejido epitelial como el conjuntivo subyacente con tejido adiposo y glándulas sudoríparas.
Visión específica: se identifica un epitelio plano pluriestratificado con diferenciación queratínica en superficie. Cuando realizamos la observación del área epitelial de superficie vemos que las células se disponen en 6-8 estratos, más por la disposición de los núcleos que no por los límites celulares, que no están bien definidos. Por su morfología y posición se identifican el estrato basal de células pequeñas y cúbicas, el espinoso constituido por células poliédricas de mayores dimensiones, el granuloso constituido por una o dos capas celulares prácticamente planas y el queratinizado en superficie con pérdida de los núcleos. En el caso del presente preparado por tratarse de una piel gruesa la cantidad de queratina en superficie es muy importante. El conjuntivo es densamente fibroso y con abundantes nervios, vasos sanguíneos de diferentes calibres, tejido adiposo blanco y glándulas sudoriparas.
Vídeo
INM-2 Piel gruesa. Células de Langerhans (CD1a) |
Utilizando técnicas de inmunohistoquímica, concretamente el CD1a, hemos puesto de manifiesto la población de células de Langerhans que se localizan entre los queratinocitos. Aparecen marcadas de color pardo negruzco en los niveles profundos e intermedios de la epidermis. Su aspecto es irregular ya que de un cuerpo ovoide parten numerosas prolongaciones citoplásmicas que se interdigitan con las células de vecindad.
 |
 |
INM-2 Langerhans (CD1a) 10x |
|
INM-2 Langerhans (CD1a) 20x |
|
 |
|
INM-2 Langerhans (CD1a) 40x |
 |
|
|
Vídeo
INM-3 Piel gruesa. Macrófagos (CD68) |
Utilizando de nuevo la técnica inmunohistoquímica, concretamente en este caso el CD 68, hemos puesto de manifiesto la población de macrófagos que se localizan en el tejido dérmico de la piel. Aparecen teñidas de un color pardo negruzco por lo que se diferencian con facilidad del resto de los componentes celulares y matriciales del conjuntivo. Su aspecto es irregular pues, al igual que las células de Langerhans que vemos en la epidermis, presentan numerosas prolongaciones citoplásmicas.
 |
 |
INM-3 Macrófagos (CD68) 20x |
|
INM-3 Macrófagos (CD68) 40x |
|
Vídeo
INM-3b Ganglio linfático. Macrófagos (CD68) |
Utilizando de nuevo la técnica inmunohistoquímica, concretamente en este caso el CD 68, hemos puesto de manifiesto la población de macrófagos que se localizan en el ganglio linfático. Aparecen teñidas de un color pardo negruzco por lo que se diferencian con facilidad del resto de los componentes celulares y matriciales del conjuntivo. Su aspecto es irregular pues, al igual que las células de Langerhans que vemos en la epidermis, presentan numerosas prolongaciones citoplásmicas.
 |
 |
INM-3b Macrófagos (CD68) 2,5x |
|
INM-3b Macrófagos (CD68) 20x |
|
Vídeo
INM-4
Ganglio linfático (Hematoxilina-eosina) |
Visión general: se analiza un ganglio linfático rodeado de tejido adiposo. En periferia se distingue el tejido conjuntivo capsular fibroso que esta perforado a nivel del hilio por la entrada y salida de los vasos sanguíneos, como por la salida del vaso linfático que recoge la linfa procesada en el mismo. Por debajo de la capsula, y en la porción convexa del ganglio, aparece el seno subcapsular como un espacio vascular que en determinados puntos es difícil de apreciar. También en esta zona se observa la cortical ganglionar con folículos secundarios y tejido linfoide difuso quedando una porción central correspondiente a la zona medular rica en vasos sanguíneos y senos linfáticos y tejido linfoide difuso cordonal.
Visión específica: en la zona cortical externa se aprecia el tejido linfoide difuso cortical con gran cantidad de elementos linfocitarios de pequeño tamaño y los folículos linfoides con su zona del manto oscura periférica y su área clara central con la característica heterogeneidad celular. La zona cortical profunda o paracorteza es el lugar en el que observamos tejido linfoide difuso y las vénulas de endotelio alto. El tejido linfoide de la médula es de tipo difuso y va acompañado de un rico componente vascular sanguíneo y linfático.
 |
 |
INM-4 Ganglio linfático 1,6x |
|
INM-4 Ganglio linfático 2,5x |
|
 |
|
INM-4 Ganglio linfático 2,5x |
 |
|
|
Vídeo
INM-5 Ganglio linfático. Linfocitos T (CD3) |
Utilizando el marcador inmunohistoquímico CD 3 hemos puesto de manifiesto la población de Linfocitos T que se localizan en el ganglio linfático. Aparecen teñidas de un color pardo negruzco por lo que se diferencian con facilidad del resto de los componentes celulares del ganglio, concretamente los linfocitos B y macrófagos que no se tiñen.
 |
 |
INM-5 Linfocitos T (CD3) 2,5x |
|
INM-5 Linfocitos T (CD3) 10x |
|
Vídeo
INM-6 Ganglio linfático. Linfocitos B (CD20) |
Utilizando el marcador inmunohistoquímico CD 20 hemos puesto de manifiesto la población de Linfocitos B que se localizan en el ganglio linfático. Aparecen teñidas de un color pardo negruzco por lo que se diferencian con facilidad del resto de los componentes celulares del ganglio, concretamente los linfocitos T y macrófagos que no se tiñen.
 |
 |
INM-6 Linfocitos B (CD20) 2,5x |
 |
INM-6 Linfocitos B (CD20) 5x |
 |
Vídeo
|